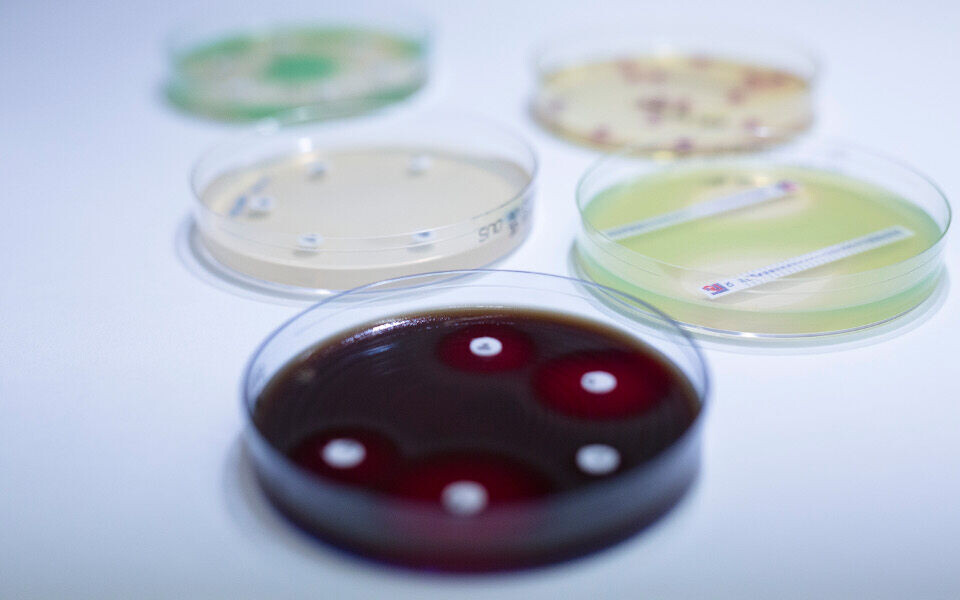

Aktuelt
Utbrudd av svært resistente bakterier i Italia, EU ønsker krisetiltak
Få slutt på "fri flyt" av pasienter over landegrenser, mener norsk professor.
I perioden november 2018 - mai 2019 er det meldt om 350 tilfeller av smitte med karbapenemaseproduserende bakterier ved italienske sykehus, opplyser Folkehelseinstituttet.
Konkret dreier det seg om Enterobacteriaceae med genet NDM-1 - New Delhi metallo-betalaktamase - som ble påvist for første gang i 2008 og gir resistens mot de fleste typer antibiotika.
EU vil ha mer kontroll
Nettstedet forskning.no skriver at EU nå ber om at sykehus i EU og EØS vurderer å registrere alle internasjonale reiser, samt tidligere sykehusinnleggelser, for hver eneste pasient som skal legges inn.
De ber også sykehusene om å vurdere å legge pasienter i isolat dersom pasientene har vært innlagt på sykehus der den aktuelle multiresistente bakterien har vært oppdaget de siste 12 månedene. EU vil også at helsemyndigheter og sykehus vurderer å teste alle pasienter som kommer fra andre land, og at det blir tatt prøver av internasjonale pasienter regelmessig under sykehusoppholdet.
Vil ha mindre "fri flyt" av pasienter
Utbruddet i Italia er en alvorlig påminnelse om konsekvensene av dårlig smittevern, mener Ørjan Olsvik, professor i medisinsk mikrobiologi ved Universitetet i Tromsø.
Til forskning.no sier han at skal vi ha håp om å få kontroll over infeksjoner med multiresistente bakterier, så må det bli slutt på fri bevegelse av pasienter mellom helseinstitusjoner i europeiske land.
Folkehelseinstituttet fraråder folk å planlegge behandling i land med høy forekomst av antibiotikaresistente bakterier, når tilsvarende behandling kan gis i Norge.